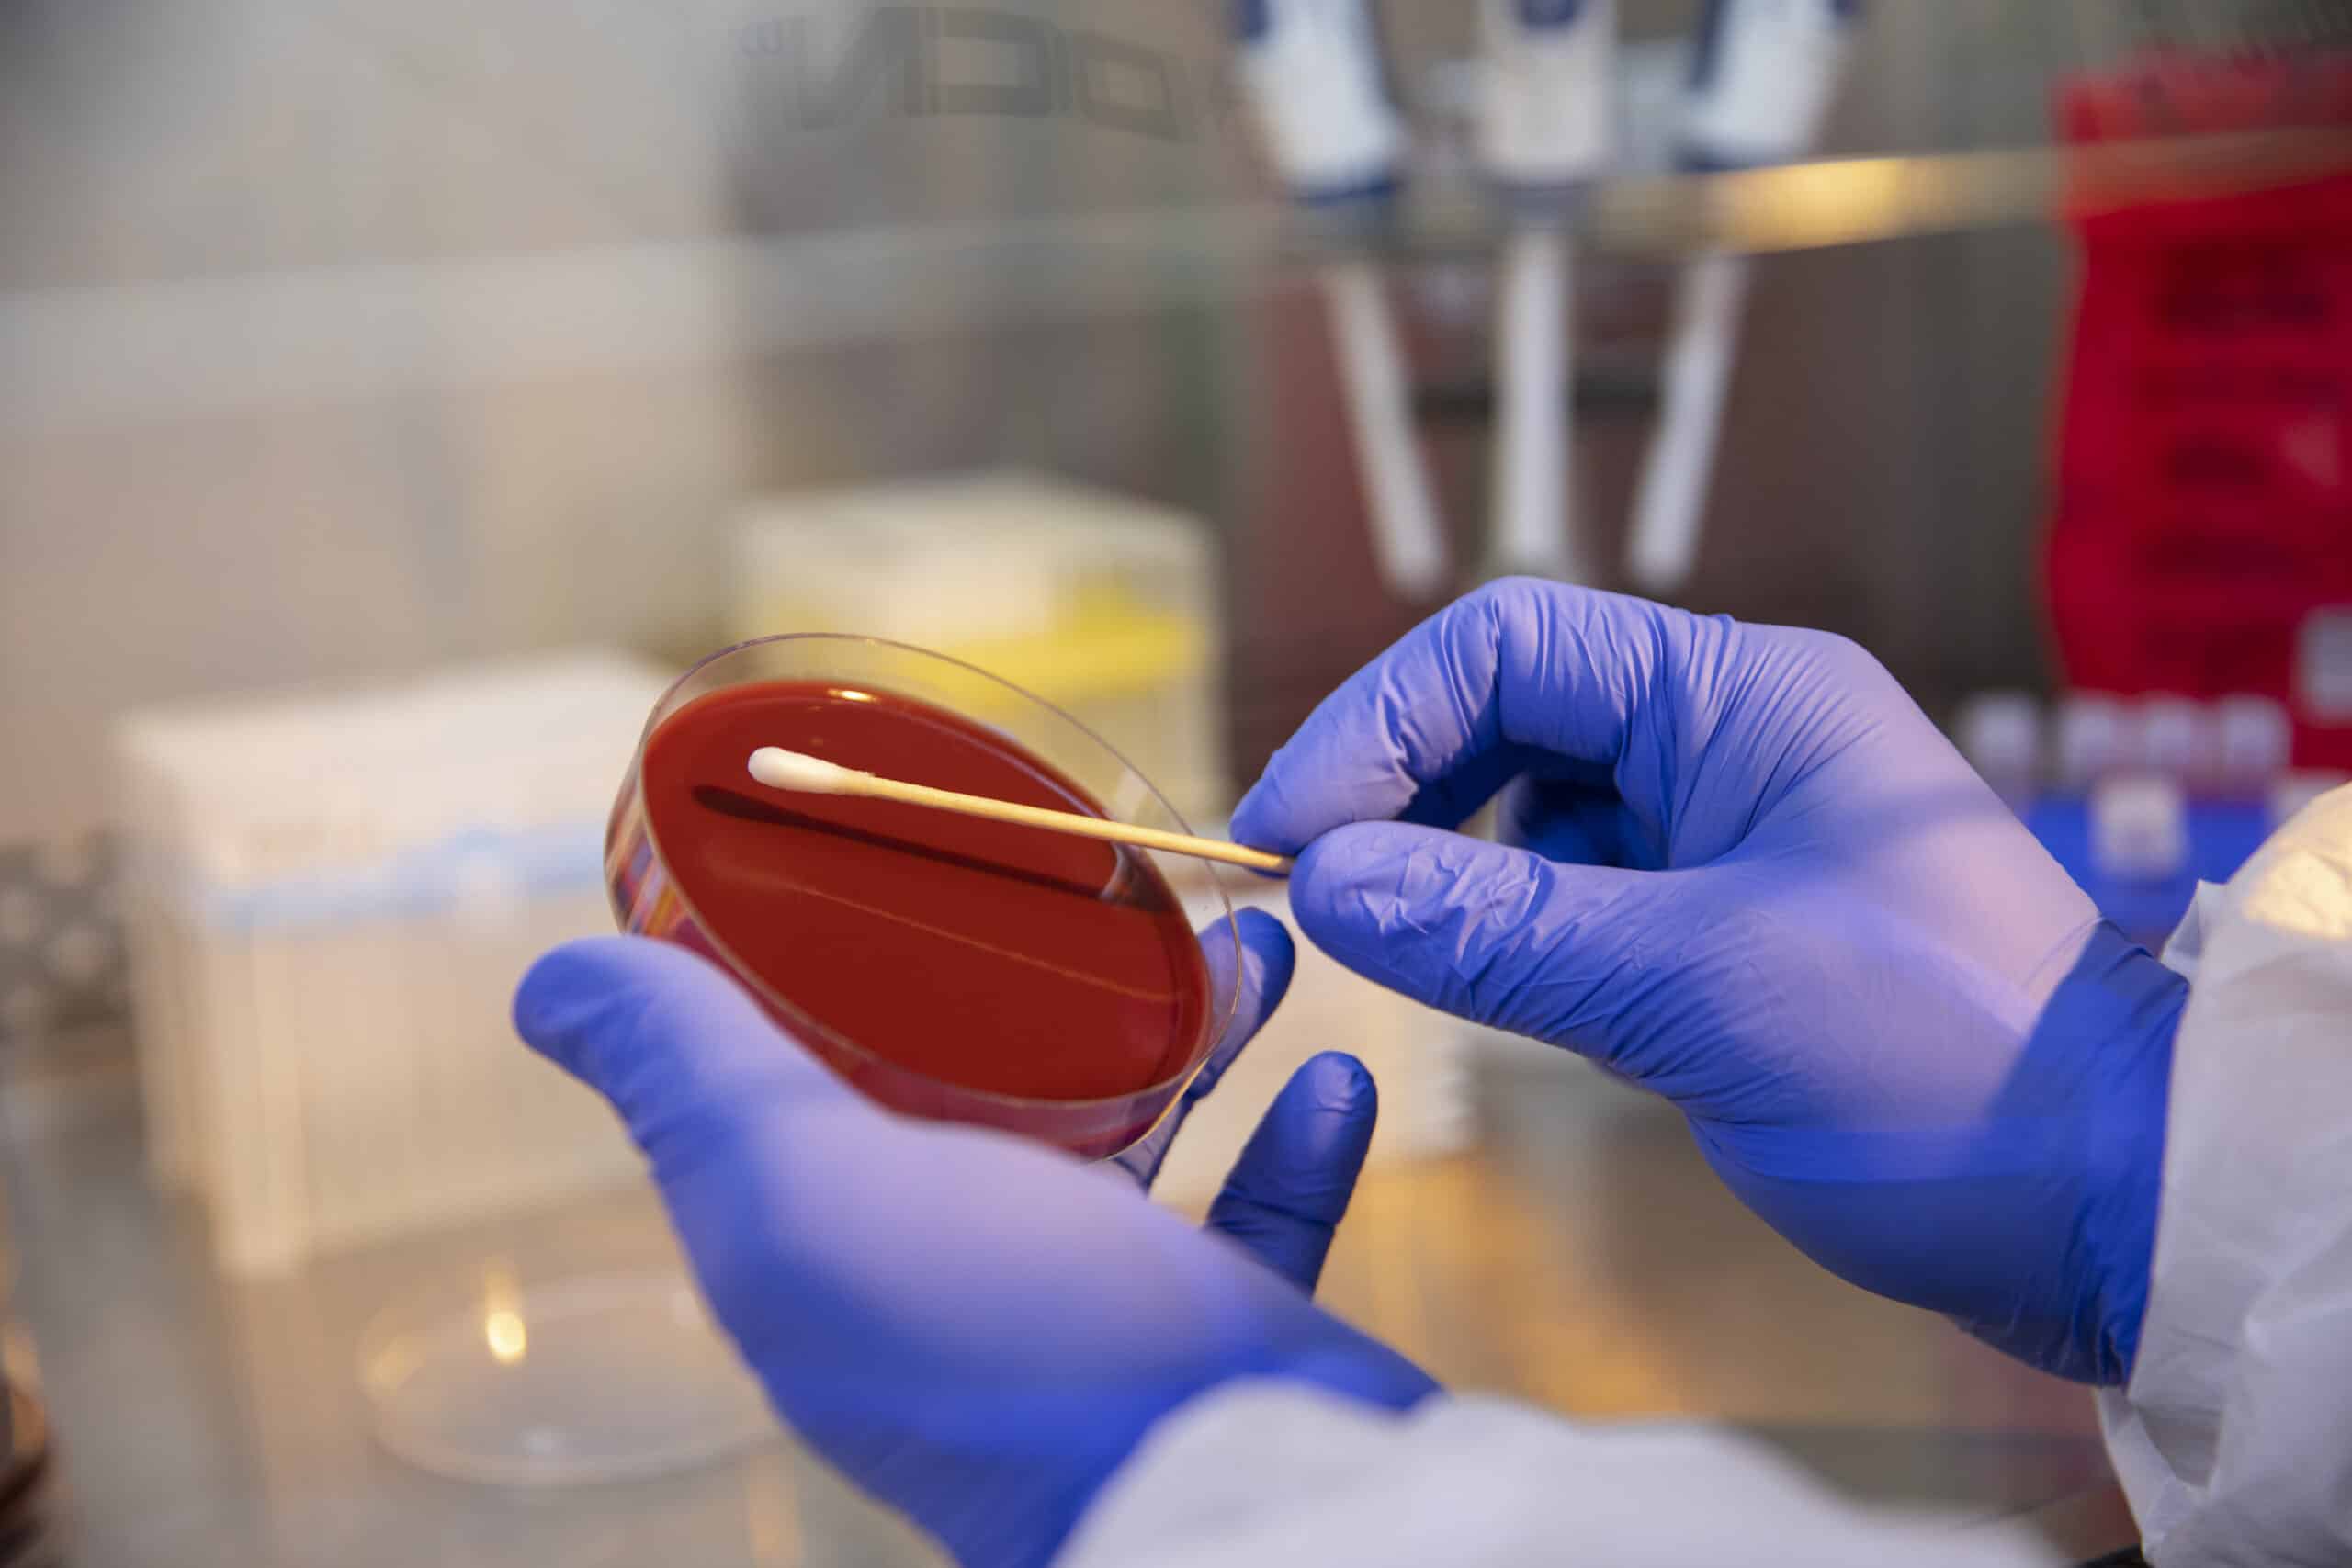

By Brandon Font, Technical Services Manager and Research Scientist, Biomed Diagnostics, a DCN Dx brand, and Pat Vaughan, Ph.D., Chief Operating Officer, DCN Dx
Introduction
As a leading provider of diagnostic solutions worldwide, Biomed Diagnostics recognizes the critical importance of addressing sustainability in healthcare and the urgent need for environmentally responsible practices. With World Environment Day serving as a poignant reminder, we are committed to developing products that not only advance patient care but also minimize the environmental impact of diagnostic processes.
The healthcare industry, while essential to the well-being of our society, is a significant contributor to environmental waste. In the United States alone, healthcare facilities generate approximately 14,000 tons (approx. 1.27 x 107 kg) of waste per day, with a substantial portion attributed to single-use items and disposable materials (Windfeld & Brooks, 2015). Microbiology laboratories rely heavily on culture media and associated consumables, which often consist of plastic and other non-biodegradable components. A study by Urbina et al. (2015) found that the microbiology laboratory in a 450-bed hospital generated an estimated 1,700 kg (1.70 x 103 kg) of plastic waste annually from culture media plates and associated packaging.
Recognizing the environmental challenges posed by traditional culture media, Biomed Diagnostics has pioneered the development of more sustainable alternatives. Our InPouch and InTray product formats exemplify our dedication to reducing waste and promoting environmental stewardship in diagnostic testing. By offering a streamlined, self-contained solution for the entire diagnostic workflow, these innovative formats minimize the use of disposable materials and enhance efficiency in the laboratory setting.
As scientists and healthcare professionals, we have a responsibility to adopt sustainable practices that mitigate the environmental impact of our work. By embracing more sustainable products, such as InPouch and InTray, we can reduce waste generation, conserve resources, and contribute to a greener future for healthcare. In this article, we will explore the unique features of our sustainable culture media formats, their potential for waste reduction, and the broader implications for environmental stewardship in the diagnostic industry.
InPouch and InTray Culture Media: Towards More Sustainable Solutions
Our InPouch and InTray culture media are designed to streamline the diagnostic workflow while reducing waste. These unique product formats allow for sampling, inoculation, transportation, and microscopic examination (depending on application) all within a single device. The InPouch system consists of a clear, oxygen-resistant plastic pouch containing a specially formulated medium, while the InTray features a compact, lightweight tray and a CO2 pellet, if applicable. By consolidating multiple steps into one device, InPouch and InTray eliminate the need for separate collection containers, transport media, and inoculation plates. This all-in-one approach not only simplifies the workflow for healthcare professionals but also significantly reduces the amount of plastic, packaging, and other materials required throughout the diagnostic process.
The InPouch and InTray formats are versatile and can be adapted to accommodate a wide range of culture media formulations specific to various pathogens. This flexibility allows for the development of tailored diagnostic solutions that meet the diverse needs of healthcare professionals and laboratories. By offering these sustainable formats across a broad spectrum of applications, Biomed Diagnostics enables the adoption of eco-friendly practices throughout the diagnostic workflow, regardless of the specific microorganisms being targeted.
The InPouch system has been successfully used for the detection of various pathogens, including Trichomonas vaginalis, a common sexually transmitted infection. Sena et al. (2007) found that the InPouch TV culture system had a sensitivity of 94.7% and a specificity of 100% for the diagnosis of T. vaginalis infection, demonstrating its reliability and effectiveness. Similarly, the InTray format has been applied to the cultivation and identification of numerous microorganisms, such as Staphylococcus aureus, a major cause of healthcare-associated infections. The InTray Colorex MRSA, a selective chromogenic medium, has shown high specificity of methicillin-resistant S. aureus (MRSA), facilitating rapid identification and isolation of this critical pathogen (van Loo et al., 2007).
Reducing Waste in Diagnostic Processes
Traditional culture media often involve multiple single-use components, such as collection swabs, transport tubes, Petri dishes, and inoculation loops. Each of these items contributes to the growing problem of medical plastic waste, which not only strains landfills but also poses risks to the environment and human health. In contrast, our InPouch and InTray systems minimize waste by providing a self-contained solution for the entire diagnostic workflow. By eliminating the need for additional containers and media, these formats can significantly reduce the volume of disposable materials used in laboratories and healthcare facilities.
The compact size and lightweight design of InPouch and InTray also make them more efficient to transport and store compared to traditional culture media. This not only reduces the environmental impact of shipping and distribution but also minimizes the space required for storage in laboratories and healthcare facilities, further contributing to waste reduction efforts.
As healthcare systems worldwide increasingly focus on reducing their environmental footprint, sustainable diagnostic solutions like InPouch and InTray are becoming more important. These innovative formats align with the growing trend of healthcare facilities implementing environmentally friendly practices, such as minimizing waste and using eco-friendly products (Hensher, 2023).
Efficiency and Convenience
Beyond their sustainability benefits, InPouch and InTray also offer practical advantages for healthcare professionals and laboratories. For example, the InPouch system’s clear, pouch allows for direct microscopic examination without the need for subculturing or additional preparation. This feature not only reduces the time to results but also minimizes the risk of contamination associated with multiple handling steps. This space-saving design is particularly valuable in settings with limited storage or incubation capacity.
Promoting Environmental Stewardship in Healthcare
As the healthcare industry increasingly recognizes its environmental responsibilities, sustainable diagnostics play a vital role in reducing the sector’s carbon footprint. By choosing products like our InPouch and InTray, healthcare facilities and laboratories demonstrate their commitment to eco-friendly practices and set an example for others to follow. Our innovative culture media formats align with global sustainability goals and initiatives, such as the United Nations’ Sustainable Development Goals (SDGs). By contributing to waste reduction and resource efficiency, InPouch and InTray support SDG 12, which calls for responsible consumption and production patterns.
Moreover, the use of sustainable culture media can help healthcare organizations meet their corporate social responsibility (CSR) goals and demonstrate their commitment to environmental stewardship. As patients, staff, and stakeholders increasingly prioritize sustainability, adopting eco-friendly diagnostic solutions like InPouch and InTray can improve an organization’s reputation and attract environmentally conscious individuals.
At Biomed, we are proud to be at the forefront of sustainable diagnostics, and we are committed to improving our products to minimize their environmental impact. By collaborating with healthcare professionals and laboratories, we aim to drive the adoption of sustainable practices throughout the industry and contribute to a healthier, more sustainable future. As we confront the global challenges of climate change and resource depletion, it is imperative that all sectors, including healthcare, prioritize sustainability. By choosing products like InPouch and InTray, diagnostics professionals can make a meaningful contribution to a greener future while continuing to deliver high-quality patient care. On this World Environment Day and beyond, let us recognize the importance of sustainable diagnostics.
References
Hensher, M. (2023). Climate change, health and sustainable healthcare: The role of health economics. Health Economics, 32(6), 973-981. https://pubmed.ncbi.nlm.nih.gov/36701185/
Sena, A. C., Miller, W. C., Hobbs, M. M., Schwebke, J. R., Leone, P. A., Swygard, H., Atashili, J., & Cohen, M. S. (2007). Trichomonas vaginalis infection in male sexual partners: implications for diagnosis, treatment, and prevention. Clinical Infectious Diseases, 44(1), 13-22. https://pubmed.ncbi.nlm.nih.gov/17143809/
Urbina MA, Watts AJR, Reardon EE. Environment: Labs should cut plastic waste too. Nature. 2015;528:479. doi: 10.1038/528479c. https://pubmed.ncbi.nlm.nih.gov/26701046/
Windfeld, E. S., & Brooks, M. S. L. (2015). Medical waste management–A review. Journal of Environmental Management, 163, 98-108. https://doi.org/10.1016/j.jenvman.2015.08.013 https://pubmed.ncbi.nlm.nih.gov/26301686/